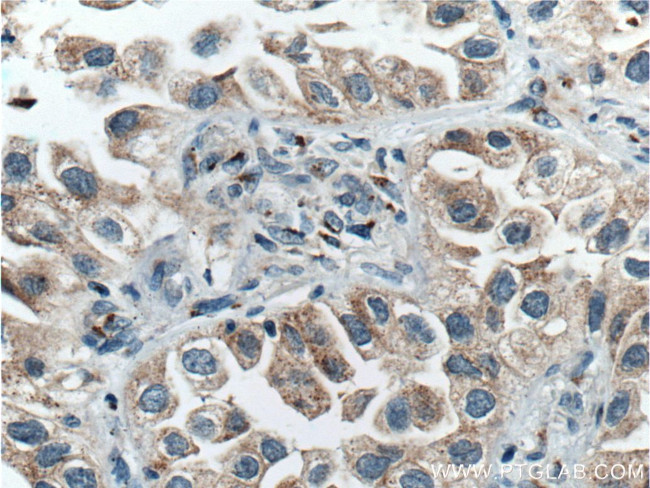
FUT8 Antibody in Immunohistochemistry (Paraffin) (IHC (P))

Search
Proteintech
FUT8 Monoclonal Antibody (2F7H2)
{{$productOrderCtrl.translations['antibody.pdp.commerceCard.promotion.promotions']}}
{{$productOrderCtrl.translations['antibody.pdp.commerceCard.promotion.viewpromo']}}
{{$productOrderCtrl.translations['antibody.pdp.commerceCard.promotion.promocode']}}: {{promo.promoCode}} {{promo.promoTitle}} {{promo.promoDescription}}. {{$productOrderCtrl.translations['antibody.pdp.commerceCard.promotion.learnmore']}}
产品信息
66118-1-IG
种属反应
已发表种属
宿主/亚型
分类
类型
克隆号
抗原
偶联物
形式
浓度
规格
纯化类型
保存液
内含物
保存条件
运输条件
产品详细信息
Immunogen sequence: HWSGEVKDK NVQVVEFPIV DSLHPRPPYL PLAVPEDLAD RLVRVHGDPA VWWVSQFVKY LIRPQPWLEK EIEEATKKLG FKHPVIGVHV RRTDKVGTEA AFHPIEEYMV HVEEHFQLLA RRMQVDKKRV YLATDDPSLL KEAKTKYPNY EFISDNSISW SAGLHNRYTE NSLRGVILDI HFLSQADFLV CTFSSQVCRV AYEIMQTLHP DASANFHSLD DIYYFGGQNA HNQIAIYAHQ PRTADEIPME PGDIIGVAGN HWDGYSKGVN RKLGRTGLYP SYKVREKIET VKYPTYPEAE K (276-575 aa encoded by BC025385)
靶标信息
Alpha-(1,6)-fucosyltransferase (FUT8) is a gene located on chromosome 14q23.3, encoding an enzyme that catalyzes the addition of fucose to N-glycans via alpha-1,6-linkage. This fucosylation is important in modifying glycoproteins, influencing their function, stability, and interactions within biological systems. FUT8 activity is crucial in various physiological processes, including immune regulation, cell signaling, and development. Aberrant fucosylation patterns, due to altered FUT8 expression, have been associated with pathological conditions such as cancer and inflammatory diseases. In oncology, FUT8-mediated core fucosylation of glycoproteins is linked to tumor progression, metastasis, and therapeutic resistance, making it a potential biomarker for cancer diagnosis and prognosis. Additionally, FUT8's role in immune function highlights its involvement in cellular communication and homeostasis, offering insights into therapeutic strategies aimed at modulating glycosylation pathways to address disease states.
仅用于科研。不用于诊断过程。未经明确授权不得转售。
生物信息学
蛋白别名: Alpha-(1,6)-fucosyltransferase; Alpha1-6FucT; EC 2.4.1.68; Fucosyltransferase 8; fucosyltransferase 8 (alpha (1,6) fucosyltransferase); GDP-fucose--glycoprotein fucosyltransferase; GDP-L-Fuc:N-acetyl-beta-D-glucosaminide alpha1,6-fucosyltransferase; Glycoprotein 6-alpha-L-fucosyltransferase; MGC26465; unnamed protein product
基因别名: CDGF; CDGF1; FUT8
UniProt ID: (Human) Q9BYC5
Entrez Gene ID: (Human) 2530